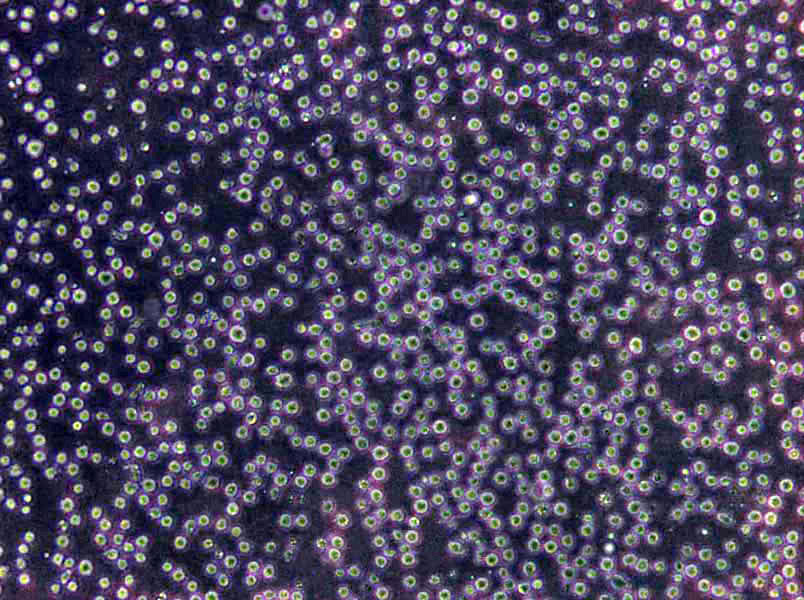
Rat1 Cells(赠送Str鉴定报告)|大鼠成纤维细胞

"Rat1 Cells(赠送Str鉴定报告)|大鼠成纤维细胞
细胞背景资料:成纤维细胞;自发永生;Fischer 344
细胞形态:成纤维细胞样
接收细胞相关问题:如不能在收到细胞后及时操作细胞,T25及离心管发货的细胞将可以消毒后在37度过夜,血清发货的细胞在室温下静置1-2天(注意不要放冰箱),干冰发货的可以在确认干冰未完全升华时将细胞直接放回液氮或者-80度冰箱,若干冰完全升华,请即刻复苏细胞。T25瓶及离心管在培养箱平衡是为了让细胞尽快适应培养箱环境,同时使部分因运输导致脱落的细胞贴壁,此步骤非常必要。T25瓶如果在显微镜下可以看到部分不贴壁的细胞,可以收集上清后离心(1200rpm,5min)后,将沉淀用新的培养基重悬后接种至新的培养瓶或皿中。部分细胞在运输过程中,由于不断震荡及环境不适,可能导致细胞破碎死亡,从而使培养基中漂浮很多细胞碎片及颗粒状物质。这种情况下,平衡后,贴壁细胞用PBS洗两遍再加新的培养基培养或者传代至新瓶中培养即可;悬浮细胞可以离心(1000rpm,3min)收集细胞,并用PBS重悬后再离心一次,再用新的培养基重悬并接种细胞。
细胞生长:贴壁
Madison细胞类似产品::RF/6A细胞、SF 126细胞、CBRH7919细胞
OCI-AML5细胞类似产品::JURKAT E-6.1细胞、HCe-8693细胞、GM07404A细胞
OV3121细胞类似产品::BCP-1细胞、NCI-BL1339细胞、Hs294细胞
RKO-AS45-1细胞类似产品::HCC0827细胞、MDA-MB-468-RED细胞、OCI Ly19细胞
MRMT-1细胞类似产品::HOEC细胞、SNU-638细胞、CORL88细胞
Rat1 Cells(赠送Str鉴定报告)|大鼠成纤维细胞
细胞物种来源:人源或鼠源等其它物种来源
[细胞产品包装]鲜活细胞:T25培养瓶(一瓶)或冻存细胞:1ml冻存管(两支)
悬浮细胞不容易转染:悬浮细胞是指细胞生长不依赖支持物表面,在培养液中呈悬浮状态生长,如淋巴细胞。在实验室经常会遇到悬浮细胞的转染,其和贴壁细胞转染还是有很大不同的。目前大多数实验室用的是脂质体类的转染试剂,脂质体转染是基于电荷吸引原理,先形成脂质体-DNA复合物,散布在细胞周围,然后通过细胞的内吞作用,将目的基因导入细胞内,而脂质体复合物与贴壁细胞的接触机会比悬浮细胞GAO出很多倍,所以,脂质体转染时悬浮细胞的转染效率要明显低于贴壁细胞。其次,脂质体试剂的毒性较大,这就使得悬浮细胞的转染更为困难了。另外,悬浮细胞不易培养,易死亡,也给细胞转染造成了一定的困难。为了提GAO悬浮细胞的转染效率,可以使用非脂质体的转染试剂,如纳米材料的。也可以使用电转染方法,针对悬浮细胞等难转染细胞还是挺不错的,电击对细胞有一定的损伤,ZuiHAO选用具有细胞膜修复功能的电转染试剂,可以将电击对细胞的伤害降到Zui低,悬浮细胞不易转染,选对试剂及良HAO的细胞培养环境才是关键。
细胞传代方法:1:2-1:3传代;每周换液2-3次。
UACC 893细胞类似产品::M2-10B4细胞、RT-BM-1细胞、293S细胞
AA-Mel细胞类似产品::SW1463细胞、L 929细胞、HT-1080细胞
SK-GT-4细胞类似产品::6-10B细胞、H1963细胞、M2-10B4细胞
SK-N-BE2C细胞类似产品::MDA-MB468细胞、TE 32.T细胞、OVCAR-432细胞
OCILY-10细胞类似产品::P3-X63-Ag8-653细胞、WM 239A细胞、Cor L51细胞
细胞来源说明:来源于RCB、ATCC、KCLB、DSMZ、ECACC、INCell、ScienCell、ECACC、JCRB、Asterand、ICLC等知名细胞库
Rat1 Cells(赠送Str鉴定报告)|大鼠成纤维细胞
细胞生长特性:贴壁
A-2780细胞类似产品::H9c2细胞、SCL-2细胞、BALL1细胞
BE(2)M17细胞类似产品::Mhh-Call 2细胞、MPP-89细胞、Normal Rat, August 3, 1983细胞
Hce8693细胞类似产品::UPCI-SCC-154细胞、ME-1 [Human leukemia]细胞、CMT-167细胞
NCI-H2171细胞类似产品::AN3细胞、Walker/LLC-WRC 256细胞、RCK8细胞
T47D细胞类似产品::AR-42J细胞、Hs895T细胞、Hs888T细胞
HC11 Mammary Epithelium细胞类似产品::F98细胞、H-1734细胞、4T1.2细胞
细胞接收后的操作流程与注意事项:1)如果细胞为贴壁细胞,而收到时呈悬浮或者部分悬浮的状态,请将悬浮的细胞即时离心,加15%血清的完全培养基到新的培养皿/瓶继续培养3天;同时原培养瓶中剩下的贴壁细胞更换为15%血清的完全培养基培养3天。3天后若原瓶或者新瓶中的细胞都没有出现增值而是继续脱落死亡,请及时联系实验室技术人员会跟进解决;2)贴壁细胞生长缓慢;适当提GAO血清浓度(ZuiGAO不能超过20%),或可根据该细胞生长密度,考虑胰酶消化后,转移到新的培养瓶继续培养;3)生长不均:贴壁细胞若出现分布不均,成岛状生长,可将细胞进行消化,重悬打散细胞,加入新鲜培养基进行培养。
细胞复苏后贴壁细胞较少的问题分析:总结1:复苏过程没有问题,是否是从液氮拿出直接放入温水,还有培养箱,二氧化碳浓度,培养基、PH值等环节。要么加GAO浓度FBS 15-20%,看看能否帮助贴壁,当然也需要考虑血清问题,还有确信拿来的细胞没问题。总结2:首先应该怀疑冻存,实际上复苏出问题的可能非常小,因为操作简单,而且死板。1、你冻存的时候是不是消化的时间过长,这是一般人所注意不到的,即使书上也不讲这个问题,太长的消化时间会让细胞复苏时失去贴壁能力,表现为先贴后死,原因是在你复苏的时候细胞已进入凋亡程序,不可逆转的死亡。2、你的冻存液HAO不HAO,是什么,甘油还是DMSO,质量非常重要,否则也会死亡。3、你的冻存液的量加的是不是太多,ATCC推荐是不超过7%,大于5%,太多也不HAO。4、你在冻存的时候是不是把DMSO混均匀,这个有一些影响,但不算太大。5、你的冻存是否按部就班,就是所温度梯度是不是把握严格,很多人容易忘却这个事情,因为这个东西流程长。6、如果你细胞污染,你是否能很快看到,我比我的导师能早一天看到污染。从这个角度讲建议去除离心这步。7、你的细胞在冻存前是否过密。还有,不赞成孵箱污染这个概念的,所有在一个孵箱里的细胞都污染一个细菌的话,这个细菌是源于孵箱的,但这不代表孵箱污染,因为孵箱无论你如何处理都有大量的细菌,问题在操作。每次污染的原因都要尽可能的找,以后就不犯同样的问题,这个很重要,不能靠猜,否则你就有可能细胞养绝Zui后换课题,这个见得太多了,别不当会事。
A2058细胞类似产品::SW-480细胞、AMC-HN8细胞、A7r5细胞
SUM 52细胞类似产品::MDA415细胞、SU86-86细胞、SKRC-20细胞
Calu-1细胞类似产品::KYSE-140细胞、BCAP37细胞、NCI-BL2141细胞
TE354T细胞类似产品::A2008细胞、RPMI6666细胞、PANC 813细胞
HO8910细胞类似产品::HEC-1B细胞、HBZY 1细胞、H-2330细胞
SUM102PT细胞类似产品::H-920细胞、TE 354.T细胞、Chang liver细胞
BrCL18细胞类似产品::MUTZ3细胞、SKMEL-2细胞、VK-2/E6E7细胞
MDAMB134VI细胞类似产品::R2C细胞、HCC0015细胞、RPMI 1846细胞
TF-1细胞类似产品::Chang liver细胞、Alexander cells细胞、hTERT RPE1细胞
BHT-101细胞类似产品::MSTO211H细胞、DV-90细胞、JeKo 1细胞
HuP-T3细胞类似产品::SK-CO-1细胞、SMMC-7721细胞、HCT-116细胞
C2C12细胞类似产品::OC 316细胞、COLO-HSR细胞、RPE D407细胞
BJA-B细胞类似产品::Y3Ag1.2.3细胞、NE-1细胞、BC-020细胞
SNU-216细胞类似产品::MHCC97-L细胞、JVM-3细胞、M-NFS-60细胞
H2066细胞类似产品::H889细胞、T-84细胞、PLA802细胞
OC-3-VGH细胞类似产品::SUDHL-6细胞、PJ34细胞、SUD-4细胞
OC-3-VGH细胞类似产品::SUDHL-6细胞、PJ34细胞、SUD-4细胞
OVCA433细胞类似产品::EC-9706细胞、JCA-1细胞、NCI-H2029细胞
Fox/NY细胞类似产品::ZR751细胞、HCS-2/8细胞、SNB-19细胞
BRL细胞类似产品::HEK293细胞、LAD 2细胞、Hs 445细胞
NCI-H1648细胞类似产品::CT26-clone 25细胞、UPCI:SCC154细胞、MSTO-211H细胞
WTRL1细胞类似产品::AAV-293细胞、H-920细胞、DanG细胞
RPMI 7951细胞类似产品::X63.Ag8.653细胞、BEAS 2B细胞、SU-DHL-4细胞
CCRF-CEM C1细胞类似产品::HIMEC细胞、FaDu细胞、HCT-GEO细胞
IR983F细胞类似产品::NK-92细胞、32D clone 3细胞、EL-4细胞
HEK293T/17细胞类似产品::SKNSH细胞、University of Arizona Cell Culture-893细胞、SUM149PT细胞
hRMECs细胞类似产品::HSAS4细胞、LSECs细胞、NCI-H1672细胞
SNU-387细胞类似产品::H-1395细胞、NCIH1105细胞、UMNSAH/DF#1细胞
P3X63-Ag8.653细胞类似产品::8226/S细胞、PC14细胞、OV3121细胞
KYSE0520细胞类似产品::Caki-1细胞、RM-1细胞、S16细胞
BAEC细胞类似产品::C28/I2细胞、H295细胞、LK2细胞
NCIH1755细胞类似产品::FET细胞、RGM-1细胞、MILE SVEN1细胞
MDA PCa 2b细胞类似产品::COLO357细胞、NCI-H78细胞、HCT/FU细胞
MFM-223细胞类似产品::SKLU-1细胞、KM12-SM细胞、P3X63Ag8-6-5-3细胞
KM-H2细胞类似产品::HMC-1细胞、CaSki细胞、KP-2细胞
ATDC5细胞类似产品::L23/P细胞、RGC-6细胞、Calf Pulmonary Artery 47细胞
HBE细胞类似产品::NCI-446细胞、RL细胞、mIMCD3细胞
KLN-205细胞类似产品::RCS细胞、H1437细胞、Centre Antoine Lacassagne-51细胞
TALL-104细胞类似产品::Mino细胞、LTEP-sm 1细胞、HEK-293-EBNA细胞
PK (15)细胞类似产品::GM07404D细胞、Hs-578T细胞、NCIH2286细胞
RT4-D6-P2T细胞类似产品::CAKI.1细胞、H-2196细胞、AR-42J细胞
Rat1 Cells(赠送Str鉴定报告)|大鼠成纤维细胞
NCI-H2227细胞类似产品::H-2286细胞、HC11细胞、FAT细胞
HS0578T细胞类似产品::L cells (TK-)细胞、TK 10细胞、MGc80-3细胞
MKN-7细胞类似产品::KM12 SM细胞、108CC15细胞、NR-8383细胞
ROS1728细胞类似产品::T_T_细胞、SW962细胞、SW 954细胞
Rat 2细胞类似产品::AR4IP细胞、TEV-1细胞、253J B-V细胞
Rat 2细胞类似产品::AR4IP细胞、TEV-1细胞、253J B-V细胞
YH细胞类似产品::NL-20细胞、Virginia Mason Research Center-Lung Cancer D细胞、NCIH596细胞
CL1-5细胞类似产品::HuH-1细胞、HEp-2细胞、SW 626细胞
H-889细胞类似产品::NCI-H1930细胞、NS-I/1细胞、SCL-1细胞
SNU668细胞类似产品::Malme-3M细胞、H-446细胞、DU 4475细胞
MGC803细胞类似产品::A2780-CP细胞、SK-GT-4细胞、CEM细胞
RPMI-1846细胞类似产品::Hs940.T细胞、NCI-HUT-125细胞、HUASMC细胞
AMO1细胞类似产品::RKO-AS-45-1细胞、MHCC 97-L细胞、OPM2细胞
HSF细胞类似产品::C3H10T1/2 clone8细胞、MGECs细胞、NCIH2106细胞
HSF细胞类似产品::C3H10T1/2 clone8细胞、MGECs细胞、NCIH2106细胞
HEL 299细胞类似产品::H2085细胞、MM.1S细胞、L-5178-Y细胞
NCI-H209细胞类似产品::RA.1细胞、H1693细胞、KBM-7细胞
AGS细胞类似产品::Glioma 261细胞、B 95.8细胞、H-596细胞
HCC0044细胞类似产品::C-4 I细胞、Hs 852.T细胞、VERO76细胞
L cell line细胞类似产品::IBMF-7细胞、Hs839T细胞、SUM102PT细胞
NCIH1155细胞类似产品::LS 1034细胞、IEC18细胞、Opossum Kidney细胞
CHP-212细胞类似产品::RGM-1细胞、NCl-H157细胞、P3-X63-Ag8-6-5-3细胞
PL12细胞类似产品::16HBE140细胞、PA-TU-8988S细胞、HIBEpiC细胞
Panc_03_27细胞类似产品::A2780/Taxol细胞、Strain KB细胞、GP293细胞
SK HEP 01细胞类似产品::HcaF细胞、Wien-133细胞、CAMA-1细胞
CTLL2细胞类似产品::HeLa-S3细胞、CCRF SB细胞、NCI-H125细胞
DLD1细胞类似产品::AgC11x3A细胞、Roswell Park Memorial Institute 1846细胞、Mahlavu细胞
IGROV 1细胞类似产品::HDF-a细胞、NCI-Hut 125细胞、OLN-93细胞
MRC-V细胞类似产品::Human Pancreatic Duct Epithelial细胞、HSC 3细胞、HO8910细胞
H-1915细胞类似产品::S180细胞、NPC-TW039细胞、Pt-K2细胞
MDA-MB-468-RED细胞类似产品::GM346细胞、Medical Research Council cell strain-5细胞、Me Wo细胞
SU8686细胞类似产品::BRL3A细胞、PANC-28细胞、LuCL4细胞
HT(H9)细胞类似产品::Jurkat E6-1细胞、PLA-801C细胞、CG-4细胞
TE4细胞类似产品::RKO_AS45细胞、SNB-19细胞、BrCL18细胞
Dami细胞类似产品::H-1954细胞、SK-NMC细胞、U-138MG细胞
Hs 578.T细胞类似产品::OUMS-23细胞、CT26WT细胞、UMUC-14细胞
H211细胞类似产品::UCLA-SO-M21细胞、HCa/16A3-F细胞、HGE细胞
T98 G细胞类似产品::Colon38细胞、MMQ细胞、32D.cl3细胞
Y1细胞类似产品::CaSki细胞、28SC细胞、LS-123细胞
TE8细胞类似产品::RASMC细胞、NKM-1细胞、PLA-801D细胞
COLO 824细胞类似产品::KY-270细胞、NP-69细胞、HEK293-EBNA细胞
CEM-C7细胞类似产品::CAL120细胞、NOMO-1细胞、Farage OL细胞
EOMA细胞类似产品::P3/NSI/1-AG4-1细胞、OB2细胞、H-548细胞
HMO6细胞类似产品::NG 108-15细胞、CNE2Z细胞、H-378细胞
293c18细胞类似产品::NCIH23细胞、UO31细胞、BC-023细胞
MHCC-97细胞类似产品::U-343细胞、LL2细胞、PTK-1细胞
H1385细胞类似产品::MM.1S细胞、MD Anderson-Metastatic Breast-175-VIII细胞、HeLa229细胞
beta-TC6细胞类似产品::BCPAP细胞、TE3细胞、Normal Rat Kidney-52E细胞
H1385细胞类似产品::MM.1S细胞、MD Anderson-Metastatic Breast-175-VIII细胞、HeLa229细胞
H-2330细胞类似产品::Soleus clone 8细胞、RL-952细胞、HEK293FT细胞
MCF10-A细胞类似产品::ME-1 [Human leukemia]细胞、SNU387细胞、SNU251细胞
H-660细胞类似产品::P3X63细胞、WM266mel细胞、Y3-Ag123细胞
A2780CP70细胞类似产品::P3 NS1 Ag4/1细胞、THLE2细胞、B16 melanoma细胞
NCIH1568细胞类似产品::THEECs细胞、118 MG细胞、RPMC细胞
NCIH1568细胞类似产品::THEECs细胞、118 MG细胞、RPMC细胞
Mono Mac6细胞类似产品::138 MG细胞、KATOIII细胞、SCC-9细胞
HCe-8693细胞类似产品::MOLM-16细胞、UACC893细胞、OCIAML5细胞
HCASMC细胞类似产品::NR-8383细胞、J-774细胞、MA-104细胞
Human Embryonic Kidney 293细胞类似产品::My-La 2059细胞、NKL细胞、NKL细胞
L-M(TK-)细胞类似产品::GB-1细胞、BALB/3T3细胞、KMM1细胞
KP-N-RT-BM-1细胞类似产品::OCIAML3细胞、KAT5细胞、578T细胞
H711细胞类似产品::IMCD-3细胞、SW 982细胞、MGHU3细胞
Ramos(RA1)细胞类似产品::IPEC-J2细胞、SK-Mel 2细胞、COLO320/DM细胞
OCILY3细胞类似产品::Madison细胞、mouse Inner Medullary Collecting Duct-3细胞、HEK AD293细胞
D341细胞类似产品::hFOB1.19细胞、CAL-120细胞、KASUMI6细胞
CA922细胞类似产品::MOLT4细胞、Mv.1.Lu细胞、SK-N-SH细胞
2V6.11细胞类似产品::IPLB-Sf21AE细胞、NCIH1299细胞、WC00044细胞
RCC23细胞类似产品::L 929细胞、BHK-21细胞、HCC-1438细胞
IALM细胞类似产品::DMS273细胞、COS7细胞、C28/I2细胞
T-84细胞类似产品::SK-RC 39细胞、HCC1500细胞、BHP10-3细胞
H676B细胞类似产品::CEM T4细胞、AN3细胞、ROS1728细胞
NCIH1781细胞类似产品::Jijoye细胞、NRK52E细胞、Sarcoma OSteogenic-2细胞
NS-I/1细胞类似产品::3T3J2细胞、WRL-68细胞、SNUC2B细胞
16-HBE细胞类似产品::MN60细胞、Transformed Human Liver Epithelial-2细胞、IPLB-Sf21-AE细胞
Kato-III细胞类似产品::Ramos 1细胞、Mel-RM细胞、ME180细胞
Swiss 3T3细胞类似产品::JROECL 19细胞、624细胞、HNE2细胞
NCTC clone 1469细胞类似产品::Hs 729T细胞、Centre Antoine Lacassagne-27细胞、WM 239细胞
NCI-H1688细胞类似产品::MOLT3细胞、P 3 HR 1细胞、CCD 1112SK细胞
IALM细胞类似产品::DMS273细胞、COS7细胞、C28/I2细胞
RK13细胞类似产品::CCLP1细胞、AMJ2C8细胞、H-2444细胞
McA-RH 7777细胞类似产品::H157细胞、Gerner 7666细胞、COR-L279细胞
Saos2细胞类似产品::BHK21细胞、CL MC/9细胞、RH-30细胞
PANC0203细胞类似产品::SK-BR3细胞、SNU423细胞、HeLa 229细胞
CCD-841CoTr细胞类似产品::Fao细胞、NuTu 19细胞、UPCI-SCC-090细胞
DoHH2细胞类似产品::VMRCRCZ细胞、KYSE 180细胞、H-2291细胞
Sf-21细胞类似产品::KAT5细胞、MiaPaca.2细胞、PC10细胞
KY70细胞类似产品::MC3T3-E1 Subclone 4细胞、SNU398细胞、Malme-3M细胞
PTK 2细胞类似产品::COLO 699细胞、NS1-Ag4/1细胞、hCMEC/D3细胞
HEI-193细胞类似产品::HNSC细胞、NIH:OVCAR-5细胞、NCI-H1819细胞
AU 565细胞类似产品::Det 562细胞、OCM1细胞、WC00097细胞
Tn-5细胞类似产品::MHCC97H细胞、AG06814-M细胞、16-HBE细胞
P388细胞类似产品::KG1细胞、H-378细胞、NH-6细胞
THLE-2细胞类似产品::TALL-1 [Human adult T-ALL]细胞、EBC-1细胞、NPC-TW039细胞
IAR20细胞类似产品::SW 1222细胞、WIL2-S细胞、NCIH1573细胞
H747细胞类似产品::SUD-4细胞、MDA MB 231细胞、SUM-52PE细胞
GB-1细胞类似产品::DLD-1细胞、RPVSMC细胞、MOLT3细胞
NS-1-Ag4-1细胞类似产品::H661细胞、Tb1Lu细胞、OUMS27细胞
H-524细胞类似产品::SRA01/04细胞、FC33细胞、Rat Glomerular Endothelial细胞
16-HBE细胞类似产品::MN60细胞、Transformed Human Liver Epithelial-2细胞、IPLB-Sf21-AE细胞
LAPC-4细胞类似产品::MESSA Dx5细胞、COR-L51细胞、B95.8细胞
C 6细胞类似产品::3T3-L1细胞、NT2D1细胞、Factor Dependent Continuous-Paterson 1细胞
UM-UC-3细胞类似产品::16HBEo-细胞、A704细胞、AN3CA细胞
NCI-HUT-69细胞类似产品::SKUT1细胞、Karpas 299细胞、H596细胞
Ramos细胞类似产品::CAL51细胞、LLC PK1细胞、NCI-SNU-182细胞
H-2066细胞类似产品::OVCA433_Bast细胞、RPMI-1788细胞、MDAMB468细胞
MDA PCa 2b细胞类似产品::COLO357细胞、HCC1187细胞、LICR-HN6细胞
H-EMC-SS细胞类似产品::He-La细胞、INS-1E细胞、H889细胞
NCI-H1650细胞类似产品::P30/0HK细胞、Normal fibroblast-10细胞、SKRC-42细胞
Human Lung Microvascular Endothelial Cell line-5a细胞类似产品::HS940细胞、S.B.细胞、Ca761细胞
HPMEC细胞类似产品::Hela-mock细胞、GEO细胞、FAK+/+细胞
LTEPsm细胞类似产品::NCI-H596细胞、ONS76细胞、LC-1/sq细胞
LCD细胞类似产品::NCI-SNU-520细胞、ISHI细胞、GM12878细胞
GM00637B细胞类似产品::Neukoplast细胞、L-M(TK-)细胞、alphaTC1 Clone 6细胞
HEK 293细胞类似产品::WM266细胞、PaTu8988s细胞、LN382细胞
Panc_08_13细胞类似产品::CCD-112CoN细胞、Jurkat 77细胞、PCI-4M细胞
Ku812F细胞类似产品::159PT细胞、GC-2细胞、CD-18细胞
T-HSC细胞类似产品::SNU-119细胞、Leghorn Male Hepatoma cell line细胞、ROS17/2.8细胞
NCIH727细胞类似产品::NCI-N87细胞、TN5B14细胞、SW1573细胞
108CC15细胞类似产品::OAW 42细胞、BHP10-3细胞、RT 112细胞
Rat1 Cells(赠送Str鉴定报告)|大鼠成纤维细胞
SU-DH-L5细胞类似产品::PC 61细胞、RetroPack PT67细胞、EBTr细胞
ReNcell CX细胞类似产品::HM06.A1细胞、U251MG细胞、P3-x63-Ag8 653细胞
NCIH1869细胞类似产品::H2.35细胞、NCI-H345细胞、NCI-H-295细胞
A-72细胞类似产品::MDA-157细胞、aTC1 Clone 6细胞、NU-GC-4细胞
Cates-1B细胞类似产品::BHK 21细胞、AAV-293细胞、DC 2.4细胞
LTEP-s细胞类似产品::IEC6细胞、CCRF-CEM/S细胞、TR 146细胞
OCILY7细胞类似产品::SNU-520细胞、PT-67细胞、Hs839T细胞
MD Anderson-Metastatic Breast-330细胞类似产品::RINm-5F细胞、3T3-Swiss albino细胞、EBC1细胞
NT2D1细胞类似产品::GAK细胞、NL20SV细胞、D10细胞
Hos TE-85细胞类似产品::MS1细胞、H650细胞、ACC3细胞
BIU-87细胞类似产品::HUT 28细胞、COLO320DM细胞、MDA-MB-468-RED细胞
H28细胞类似产品::H1618细胞、HOK细胞、V79-GalK1细胞
SHIN3细胞类似产品::HO8910PM细胞、H187细胞、PC 61细胞
RMC-1细胞类似产品::VM-CUB-I细胞、LC-1-sq细胞、HuT102细胞
HPAF II细胞类似产品::MD Anderson-Metastatic Breast-134-VI细胞、Caki-1细胞、NUGC2细胞
Hs706T细胞类似产品::SR786细胞、JC细胞、Panc02细胞
NCI-H498细胞类似产品::RPE1-hTERT细胞、B16 subline B78细胞、22Rv-1细胞
M109细胞类似产品::JAR细胞、RGC5细胞、Hs895.T细胞
RWPE-1细胞类似产品::NCI-H2073细胞、EFM192A细胞、TE3细胞
Monomac-1细胞类似产品::H2228细胞、Panc 10.05细胞、SUM190细胞
B16 F10细胞类似产品::A-704细胞、253JBV细胞、LNCaP subline C4-2细胞
K-562细胞类似产品::GFP-Olig2细胞、Colo205细胞、H3255细胞
NCI-H2108细胞类似产品::COLO 684细胞、D6P2T细胞、University of Arizona Cell Culture-893细胞
NIH-3T3细胞类似产品::TM-4细胞、CAL-85-1细胞、HA1800细胞
VCaP细胞类似产品::Hs274T细胞、LNCaP-C4-2细胞、SKOV-3细胞
HeLaS3细胞类似产品::KP-N-RT-BM细胞、HCC0202细胞、AC29细胞
NCIH1105细胞类似产品::ST 486细胞、CT26.WT细胞、H-1299细胞
OVCAR-3细胞类似产品::TE10细胞、SW1417细胞、LN-382细胞
SNU-5细胞类似产品::SKLU01细胞、UCLA SO M14细胞、IA-LM细胞
RTMC细胞类似产品::PL 45细胞、L-cell细胞、CEMO-1细胞
Calu-1细胞类似产品::KYSE-140细胞、SU-DHL-8细胞、HT 29细胞
GM03320细胞类似产品::NCIH1781细胞、UACC 812细胞、TKB1细胞
"